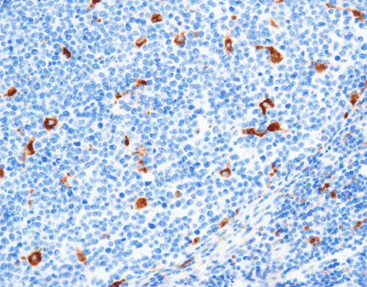

PRODUCT CATEGORY
PRODUCT CATEGORY
CONTACT US
Phone
Email
Address
6 Cuizhu St, Zhong Yuan Qu, Zheng Zhou Shi, He Nan Sheng, China, 450001
CD68(C2F10),MMab
CD68 primarily targets macrophages in a variety of tissues, including Kuffer cells in the liver.It is mainly used for the diagnosis of acute and chronic myeloid leukemia and tissue-derived tumors such as malignant fibrohistiocytoma, but it is often detected simultaneously with AACT and Lysozyme to improve its diagnostic accuracy.
Staining Tissue
[As Figure shows]
Tonsil tissue stained with CD68
[Intended Use]
CD68 primarily targets macrophages in a variety of tissues, including Kuffer cells in the liver.It is mainly used for the diagnosis of acute and chronic myeloid leukemia and tissue-derived tumors such as malignant fibrohistiocytoma, but it is often detected simultaneously with AACT and Lysozyme to improve its diagnostic accuracy.
[Specifications]
| Product Name | CD68(C2F10),MMab |
| Catalog No. | CCM-0701 |
| Intended Use | IVD, RUO |
| Species Reactivity | Human; others not tested |
| Cellular Localization | Cytoplasm / Nucleus |
| Antibody Type | Mouse Monoclonal |
| Clone | Kp-1 |
| Format and Volume | Ready-to-use: 1mL, 3mL, 6mL Concentrated: 0.1mL, 0.2mL and 1mL |
[Datasheets & SDS]
| IVD Datasheet (IFU) | ↕️ Download |
| RUO Datasheet (IFU) | ↕️ Download |
| SDS sheet | check with sales |
[Storage and Validity]
Store at 2~8°C. Avoid freezing.
Maintain temperature below room temperature during transport, ensuring it does not exceed one week.